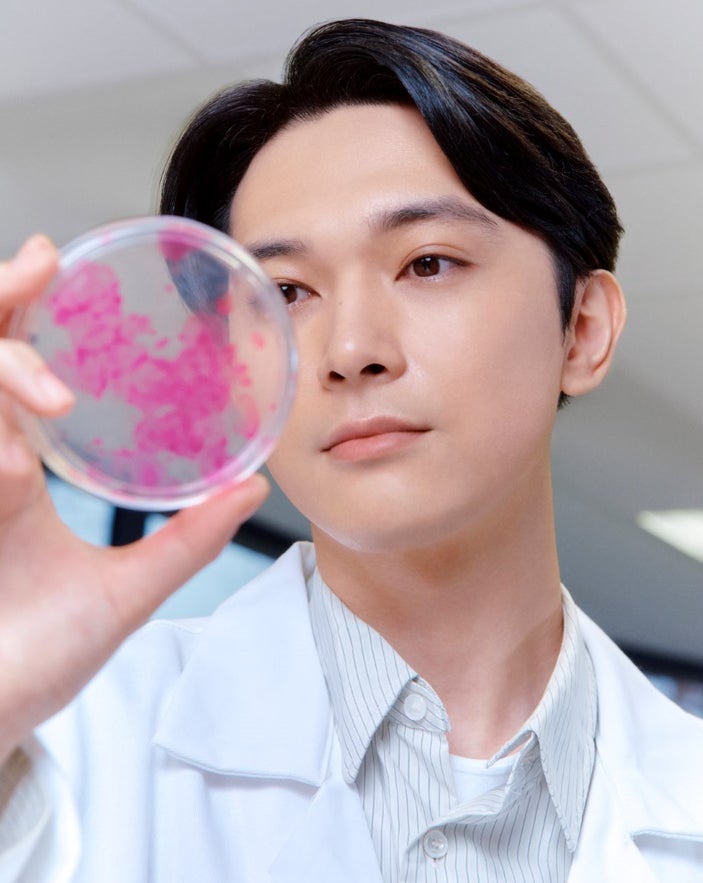

- 吉沢亮がディオールのアンバサダーとして出演
- ディオールの研究開発現場に潜入し、製品開発の裏側をレポート
- カプチュール トータルの進化を体現し、さらなる飛躍を目指す
- カプチュール トータルは幹細胞研究から生まれたスキンケアライン
- ル セラムやヒアルショットも発売
- 吉沢亮は俳優としても活躍し、主演映画『ぼくが生きてる、ふたつの世界』が2024年に公開予定
ディオール ビューティーのアンバサダーである吉沢亮が、ディオールのカプチュール トータルのスペシャルムービーに出演します。
彼はフランスの「エリオス研究所」を訪れ、ディオールの研究開発の現場に潜入します。
彼は研究員たちと協力しながら、幹細胞の観察や原料の調合など、製品開発の裏側をレポートします。
また、彼の肌測定も行われ、彼のスキンケアルーティンや美肌の秘訣も紹介されます。
吉沢亮はカプチュール トータルの進化を体現し、さらなる飛躍を目指しています。
詳細はDior.comで公開されます。
カプチュール トータルは、20年以上の幹細胞研究から生まれたスキンケアラインであり、若々しい美肌を実現する美容液「ル セラム」やヒアルロン酸補充美容液「ヒアルショット」も発売されます。
吉沢亮は俳優としても活躍し、数々の話題作に出演しています。
彼の主演映画『ぼくが生きてる、ふたつの世界』は2024年に公開予定です。

- 会社
- ディオール、エリオス研究所
- 人物
- 吉沢亮
- 製品名
- カプチュール トータル
- 商品名
- ル セラム、ヒアルショット
- 映画
- ぼくが生きてる、ふたつの世界
引用元: https://prtimes.jp/main/html/rd/p/000000437.000014810.html

